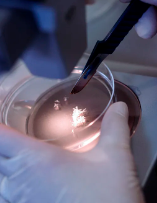
image.png

墨爾本大學(xué)骨骼干細(xì)胞研究方向
2024-11-10 11:46:46 來源: 小編 咨詢醫(yī)生
墨爾本大學(xué)作為澳大利亞頂尖的學(xué)術(shù)研究機(jī)構(gòu),其在骨骼干細(xì)胞研究方面取得了舉世矚目的成果。骨骼干細(xì)胞是一種具有多能分化潛能的細(xì)胞,可以分化為骨骼、軟骨、脂肪等細(xì)胞類型,對(duì)于骨骼再生、骨折修復(fù)等領(lǐng)域具有極高的研究?jī)r(jià)值。
一、骨骼干細(xì)胞研究背景
骨骼干細(xì)胞研究始于20世紀(jì)90年代,當(dāng)時(shí)科學(xué)家們發(fā)現(xiàn)了一種具有多能分化潛能的細(xì)胞,可以分化為骨骼和軟骨等細(xì)胞類型。隨后,研究者們開始關(guān)注這種細(xì)胞在骨折修復(fù)、骨骼疾病治療等方面的應(yīng)用。墨爾本大學(xué)在這一領(lǐng)域的研究具有很高的起點(diǎn),為國(guó)際骨骼干細(xì)胞研究做出了重要貢獻(xiàn)。
二、墨爾本大學(xué)骨骼干細(xì)胞研究方向
1.骨骼干細(xì)胞來源
墨爾本大學(xué)的研究團(tuán)隊(duì)致力于尋找骨骼干細(xì)胞的最佳來源。他們發(fā)現(xiàn),骨髓、脂肪組織和肌肉等組織中均存在骨骼干細(xì)胞,但骨髓來源的骨骼干細(xì)胞分化潛能最高。因此,研究者們將重點(diǎn)放在了骨髓來源的骨骼干細(xì)胞上。
2.骨骼干細(xì)胞分化調(diào)控
墨爾本大學(xué)的研究團(tuán)隊(duì)深入研究了骨骼干細(xì)胞分化的調(diào)控機(jī)制。他們發(fā)現(xiàn),多種細(xì)胞因子、生長(zhǎng)因子和信號(hào)通路在骨骼干細(xì)胞分化過程中發(fā)揮重要作用。這些研究成果為骨骼干細(xì)胞的應(yīng)用提供了理論基礎(chǔ)。
3.骨骼干細(xì)胞移植
研究者們還關(guān)注了骨骼干細(xì)胞移植在骨折修復(fù)和骨骼疾病治療中的應(yīng)用。他們發(fā)現(xiàn),通過將骨骼干細(xì)胞移植到受損部位,可以促進(jìn)骨骼再生,加快骨折愈合過程。此外,骨骼干細(xì)胞移植還有助于治療某些骨骼疾病,如骨質(zhì)疏松癥、骨關(guān)節(jié)炎等。
4.骨骼干細(xì)胞與生物材料
墨爾本大學(xué)的研究團(tuán)隊(duì)還探討了骨骼干細(xì)胞與生物材料相互作用的研究。他們發(fā)現(xiàn),生物材料可以作為一種支架,為骨骼干細(xì)胞提供生長(zhǎng)和分化的環(huán)境。這些研究成果為骨骼干細(xì)胞的應(yīng)用提供了新的思路。
三、未來發(fā)展趨勢(shì)
隨著研究的深入,墨爾本大學(xué)骨骼干細(xì)胞研究團(tuán)隊(duì)將重點(diǎn)關(guān)注以下幾個(gè)方面:
1.骨骼干細(xì)胞的制備和擴(kuò)增技術(shù),以提高其分化潛能和移植效果。
2.骨骼干細(xì)胞治療的安全性評(píng)價(jià),確保其在臨床應(yīng)用中的安全性。
3.骨骼干細(xì)胞與生物材料的結(jié)合,開發(fā)新型骨骼修復(fù)材料。
4.骨骼干細(xì)胞治療骨折、骨骼疾病等臨床應(yīng)用的拓展。
總之,墨爾本大學(xué)在骨骼干細(xì)胞研究方向取得了顯著成果,為我國(guó)骨骼干細(xì)胞研究提供了有益借鑒。未來,這一領(lǐng)域的研究將為骨骼疾病治療帶來更多突破,造福廣大患者。
- 2024-10-16全能干細(xì)胞有哪些,干細(xì)胞分幾種都有哪些功能
- 2024-10-14大口徑干細(xì)胞容器生產(chǎn)商
- 2024-11-04干細(xì)胞營(yíng)銷手段有哪些創(chuàng)新方法?研究進(jìn)展如何?
- 2024-10-16安徽干細(xì)胞培訓(xùn)機(jī)構(gòu)哪家強(qiáng)?排名及課程介紹!
- 2024-11-09捐獻(xiàn)造血干細(xì)胞是骨髓移植嗎?
- 2024-11-12自體干細(xì)胞移植有全過程嗎,費(fèi)用多少錢
- 2024-09-28山西的干細(xì)胞重組培訓(xùn)機(jī)構(gòu)哪家強(qiáng)?
- 2024-10-10干細(xì)胞海河醫(yī)院治療成果如何?一文揭秘
- 2024-09-10干細(xì)胞填淚溝效果好嗎,能維持多久
- 2024-08-20間充質(zhì)干細(xì)胞從哪里提取,提取全過程講解
- 2024-07-19糖尿病干細(xì)胞移植能治好嗎,糖尿病干細(xì)胞移植多少錢
- 2024-10-10干細(xì)胞及基因編輯技術(shù)哪家強(qiáng)?前沿研究揭秘
- 2024-09-22干細(xì)胞治療肝硬化有效果嗎?費(fèi)用多少
- 2024-07-21干細(xì)胞移植后能活30年,注射干細(xì)胞使人長(zhǎng)壽嗎
- 2024-08-01干細(xì)胞去眼袋價(jià)格,干細(xì)胞去眼袋能保持幾年
- 2024-08-05干細(xì)胞治療費(fèi)用,干細(xì)胞治療的風(fēng)險(xiǎn)大嗎
- 2024-07-23北京301醫(yī)院干細(xì)胞,北京301干細(xì)胞移植怎么樣
- 2024-10-09干細(xì)胞注射抗衰老真的有用嗎?國(guó)內(nèi)哪些機(jī)構(gòu)技術(shù)成熟?
